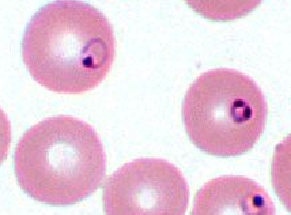
knowt flashcard image
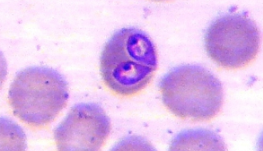
knowt flashcard image
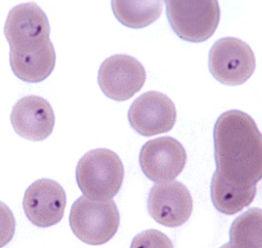
knowt flashcard image

Parasite Identification
0.0(0)
Card Sorting
1/35
Earn XP
Description and Tags
VET 350 egg ID (common names)
Last updated 3:33 AM on 9/16/25
Name | Mastery | Learn | Test | Matching | Spaced | Call with Kai |
|---|
No analytics yet
Send a link to your students to track their progress
36 Terms
1
New cards
lung fluke in dogs and cats

2
New cards
double-pored tapeworm

3
New cards
zipper tapeworm

4
New cards
roundworm

5
New cards
hookworm

6
New cards
whipworm

7
New cards
heartworm

8
New cards
Taenia spp.

9
New cards
Giardia spp. trophozoite

10
New cards
Giardia spp. cyst

11
New cards
Capillaria spp.

12
New cards
cystoisospora spp.

13
New cards
Toxoplasma gondii

14
New cards
Hepatozoon spp.

15
New cards
Babesia gibsoni
16
New cards
Babesia canis
17
New cards
Cytauxzoon felis
18
New cards
equine roundworm

19
New cards
equine pinworm

20
New cards
ruminant tapeworm

21
New cards
Equine Stomach Worm

22
New cards
Strongyle

23
New cards
Equine Tapeworm

24
New cards
Liver Fluke

25
New cards
Brown Stomach Worm

26
New cards
Sucking lice

27
New cards
Chewing Lice

28
New cards
Sarcoptes scabei

29
New cards
Demodex

30
New cards
Ear mite

31
New cards
Assassin bug

32
New cards
Flea

33
New cards
Phlebotomine Sand Fly
Phlebotomine Sand Fly

34
New cards
Warble fly

35
New cards
Screw worm fly

36
New cards
Sheep ked
